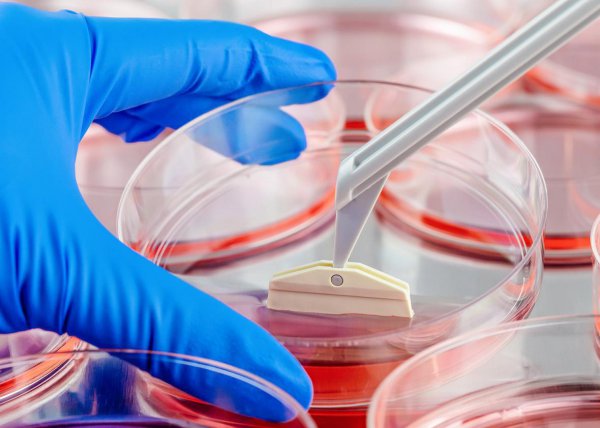
海拉细胞为什么会永生

海拉细胞为什么会永生 海拉的细胞是怎么活这么久的(2)

当然如你所想,化疗也会杀死健康细胞,当时医学界正在极力改善这一现象,为之努力的也有约翰·霍普金斯医院的理查德·韦斯利·特林德。
他抓住这个机会从拉克斯身上取得了宫颈鳞状细胞,当然拉克斯不可能知情,她一直以为都是医院检查需要!

接受治疗后,拉克斯离开了医院,而这种细胞则在实验室里被标上了“HeLa”(海拉),就是拉克斯名字的缩写,从次以后便开始了海拉细胞的开挂生涯。
原先实验室的研究人员会以为这些细胞很快就会死掉,但海拉细胞显然超出了他们的预料,只要给予简单的培养环境,海拉细胞每天就会翻倍,几天内就长满了培养皿。
相关阅读
-

品牌水杯十大名牌排名 实用好看的十大品牌杯子推荐
如果想了解品牌水杯十大名牌排名方面的内容,接下来常识社小编为大家介绍。 将会介绍到的杯子品牌: Drink in the Box Monbento水杯 NUOC水杯 韩国乐扣乐扣 Kinto日本家居品牌 Joseph Joseph THERMOS膳魔
-

为什么82年的拉菲最贵 为什么都说82年的拉菲最好
常识社网小编为你介绍为什么都说82年的拉菲最好和为什么82年的拉菲最贵的相关知识,接下来常识社网小编就来介绍。 受商品竞争、收藏价值等因素的影响,正宗拉菲的价格每年都会波动。
-

家长送给老师最实用的礼物 这几种礼物不费钱老师也不为难
正文核心导读:这几种礼物不费钱老师也不为难和家长送给老师最实用的礼物的小经验,接下来小编为您详细解答 教师节给老师送这几种礼物,既不费钱,老师也不为难,还特显心意! 教师是
-

早上好立冬文案短句 立冬的文案句子
今天介绍早上好立冬文案短句方面的介绍,一起来了解了解吧。 立冬到,问个好,愿你心情好,快乐幸福没烦恼,愿你精神好,舒心顺心更开心,愿你身体好,平安如意身体健,愿你生活好,


